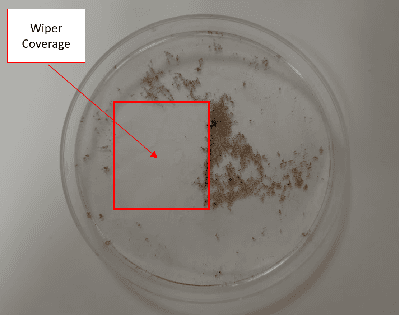
Figure 2 for Design of magnetic coupling-based anti-biofouling mechanism for underwater optical sensors

Abstract:Underwater image dehazing is critical for vision-based marine operations because light scattering and absorption can severely reduce visibility. This paper introduces snnTrans-DHZ, a lightweight Spiking Neural Network (SNN) specifically designed for underwater dehazing. By leveraging the temporal dynamics of SNNs, snnTrans-DHZ efficiently processes time-dependent raw image sequences while maintaining low power consumption. Static underwater images are first converted into time-dependent sequences by repeatedly inputting the same image over user-defined timesteps. These RGB sequences are then transformed into LAB color space representations and processed concurrently. The architecture features three key modules: (i) a K estimator that extracts features from multiple color space representations; (ii) a Background Light Estimator that jointly infers the background light component from the RGB-LAB images; and (iii) a soft image reconstruction module that produces haze-free, visibility-enhanced outputs. The snnTrans-DHZ model is directly trained using a surrogate gradient-based backpropagation through time (BPTT) strategy alongside a novel combined loss function. Evaluated on the UIEB benchmark, snnTrans-DHZ achieves a PSNR of 21.68 dB and an SSIM of 0.8795, and on the EUVP dataset, it yields a PSNR of 23.46 dB and an SSIM of 0.8439. With only 0.5670 million network parameters, and requiring just 7.42 GSOPs and 0.0151 J of energy, the algorithm significantly outperforms existing state-of-the-art methods in terms of efficiency. These features make snnTrans-DHZ highly suitable for deployment in underwater robotics, marine exploration, and environmental monitoring.




Abstract:Underwater image enhancement (UIE) is fundamental for marine applications, including autonomous vision-based navigation. Deep learning methods using convolutional neural networks (CNN) and vision transformers advanced UIE performance. Recently, spiking neural networks (SNN) have gained attention for their lightweight design, energy efficiency, and scalability. This paper introduces UIE-SNN, the first SNN-based UIE algorithm to improve visibility of underwater images. UIE-SNN is a 19- layered convolutional spiking encoder-decoder framework with skip connections, directly trained using surrogate gradient-based backpropagation through time (BPTT) strategy. We explore and validate the influence of training datasets on energy reduction, a unique advantage of UIE-SNN architecture, in contrast to the conventional learning-based architectures, where energy consumption is model-dependent. UIE-SNN optimizes the loss function in latent space representation to reconstruct clear underwater images. Our algorithm performs on par with its non-spiking counterpart methods in terms of PSNR and structural similarity index (SSIM) at reduced timesteps ($T=5$) and energy consumption of $85\%$. The algorithm is trained on two publicly available benchmark datasets, UIEB and EUVP, and tested on unseen images from UIEB, EUVP, LSUI, U45, and our custom UIE dataset. The UIE-SNN algorithm achieves PSNR of \(17.7801~dB\) and SSIM of \(0.7454\) on UIEB, and PSNR of \(23.1725~dB\) and SSIM of \(0.7890\) on EUVP. UIE-SNN achieves this algorithmic performance with fewer operators (\(147.49\) GSOPs) and energy (\(0.1327~J\)) compared to its non-spiking counterpart (GFLOPs = \(218.88\) and Energy=\(1.0068~J\)). Compared with existing SOTA UIE methods, UIE-SNN achieves an average of \(6.5\times\) improvement in energy efficiency. The source code is available at \href{https://github.com/vidya-rejul/UIE-SNN.git}{UIE-SNN}.




Abstract:This study presents acoustic-based methods for the control of multiple autonomous underwater vehicles (AUV). This study proposes two different models for implementing boundary and path control on low-cost AUVs using acoustic communication and a single central acoustic beacon. Two methods are presented: the Range Variation-Based (RVB) model completely relies on range data obtained by acoustic modems, whereas the Heading Estimation-Based (HEB) model uses ranges and range rates to estimate the position of the central boundary beacon and perform assigned behaviors. The models are tested on two boundary control behaviors: Fencing and Milling. Fencing behavior ensures AUVs return within predefined boundaries, while Milling enables the AUVs to move cyclically on a predefined path around the beacon. Models are validated by successfully performing the boundary control behaviors in simulations, pool tests, including artificial underwater currents, and field tests conducted in the ocean. All tests were performed with fully autonomous platforms, and no external input or sensor was provided to the AUVs during validation. Quantitative and qualitative analyses are presented in the study, focusing on the effect and application of a multi-robot system.
Abstract:This paper introduces the concept of employing neuromorphic methodologies for task-oriented underwater robotics applications. In contrast to the increasing computational demands of conventional deep learning algorithms, neuromorphic technology, leveraging spiking neural network architectures, promises sophisticated artificial intelligence with significantly reduced computational requirements and power consumption, emulating human brain operational principles. Despite documented neuromorphic technology applications in various robotic domains, its utilization in marine robotics remains largely unexplored. Thus, this article proposes a unified framework for integrating neuromorphic technologies for perception, pose estimation, and haptic-guided conditional control of underwater vehicles, customized to specific user-defined objectives. This conceptual framework stands to revolutionize underwater robotics, enhancing efficiency and autonomy while reducing energy consumption. By enabling greater adaptability and robustness, this advancement could facilitate applications such as underwater exploration, environmental monitoring, and infrastructure maintenance, thereby contributing to significant progress in marine science and technology.




Abstract:This paper delves into the potential of DU-VIO, a dehazing-aided hybrid multi-rate multi-modal Visual-Inertial Odometry (VIO) estimation framework, designed to thrive in the challenging realm of extreme underwater environments. The cutting-edge DU-VIO framework is incorporating a GAN-based pre-processing module and a hybrid CNN-LSTM module for precise pose estimation, using visibility-enhanced underwater images and raw IMU data. Accurate pose estimation is paramount for various underwater robotics and exploration applications. However, underwater visibility is often compromised by suspended particles and attenuation effects, rendering visual-inertial pose estimation a formidable challenge. DU-VIO aims to overcome these limitations by effectively removing visual disturbances from raw image data, enhancing the quality of image features used for pose estimation. We demonstrate the effectiveness of DU-VIO by calculating RMSE scores for translation and rotation vectors in comparison to their reference values. These scores are then compared to those of a base model using a modified AQUALOC Dataset. This study's significance lies in its potential to revolutionize underwater robotics and exploration. DU-VIO offers a robust solution to the persistent challenge of underwater visibility, significantly improving the accuracy of pose estimation. This research contributes valuable insights and tools for advancing underwater technology, with far-reaching implications for scientific research, environmental monitoring, and industrial applications.
Abstract:In this paper we show the application of the new robotic multi-platform system HSURF to a specific use case of teleoperation, aimed at monitoring and inspection. The HSURF system, consists of 3 different kinds of platforms: floater, sinker and robotic fishes. The collaborative control of the 3 platforms allows a remotely based operator to control the fish in order to visit and inspect several targets underwater following a complex trajectory. A shared autonomy solution shows to be the most suitable, in order to minimize the effect of limited bandwidth and relevant delay intrinsic to acoustic communications. The control architecture is described and preliminary results of the acoustically teleoperated visits of multiple targets in a testing pool are provided.




Abstract:There has been a growing interest in extending the capabilities of autonomous underwater vehicles (AUVs) in subsea missions, particularly in integrating underwater human-robot interaction (UHRI) for control. UHRI and its subfield,underwater gesture recognition (UGR), play a significant role in enhancing diver-robot communication for marine research. This review explores the latest developments in UHRI and examines its promising applications for multi-robot systems. With the developments in UGR, opportunities are presented for underwater robots to work alongside human divers to increase their functionality. Human gestures creates a seamless and safe collaborative environment where divers and robots can interact more efficiently. By highlighting the state-of-the-art in this field, we can potentially encourage advancements in underwater multi-robot system (UMRS) blending the natural communication channels of human-robot interaction with the multi-faceted coordination capabilities of underwater swarms,thus enhancing robustness in complex aquatic environments.




Abstract:Spiking neural networks are becoming increasingly popular for their low energy requirement in real-world tasks with accuracy comparable to the traditional ANNs. SNN training algorithms face the loss of gradient information and non-differentiability due to the Heaviside function in minimizing the model loss over model parameters. To circumvent the problem surrogate method uses a differentiable approximation of the Heaviside in the backward pass, while the forward pass uses the Heaviside as the spiking function. We propose to use the zeroth order technique at the neuron level to resolve this dichotomy and use it within the automatic differentiation tool. As a result, we establish a theoretical connection between the proposed local zeroth-order technique and the existing surrogate methods and vice-versa. The proposed method naturally lends itself to energy-efficient training of SNNs on GPUs. Experimental results with neuromorphic datasets show that such implementation requires less than 1 percent neurons to be active in the backward pass, resulting in a 100x speed-up in the backward computation time. Our method offers better generalization compared to the state-of-the-art energy-efficient technique while maintaining similar efficiency.




Abstract:The goal of this work is to apply a denoising image transformer to remove the distortion from underwater images and compare it with other similar approaches. Automatic restoration of underwater images plays an important role since it allows to increase the quality of the images, without the need for more expensive equipment. This is a critical example of the important role of the machine learning algorithms to support marine exploration and monitoring, reducing the need for human intervention like the manual processing of the images, thus saving time, effort, and cost. This paper is the first application of the image transformer-based approach called "Pre-Trained Image Processing Transformer" to underwater images. This approach is tested on the UFO-120 dataset, containing 1500 images with the corresponding clean images.

Abstract:Water monitoring is crucial for environmental monitoring, transportation, energy and telecommunication. One of the main problems in aquatic environmental monitoring is biofouling. The simplest method among the current antifouling strategies is the use of wiper technologies like brushes and wipers which apply mechanical pressure. In designing built-in strategies however, manufacturers usually build the sensor around the biofouling system. The current state-of-the-art is a fully integrated central wiper in the sensor that enables cleaning of all probes mounted on the sonde. Improvements in antifouling strategies lag rapid advancements in sensor technologies such as in miniaturization, specialization, and costs. Hence, improving built-in designs by decreasing size and complexity will decrease maintenance and overall costs. This design is targeted for the EU project Robocoenosis since bio-hybrid systems in this project incorporate living organisms. This technology targets selective proliferation of the organisms which only prevents biofilms on components where they are unwanted. Beyond this, the use of autonomous activation based on image processing may likely be advantageous for minimizing the need for human inspection and maintenance. In addition to Robocoenosis, we also aim at incorporating this design in another project entitled Heterogeneous Swarm of Underwater Autonomous Vehicles where a swarm of heterogeneous underwater robotic fish is being developed.